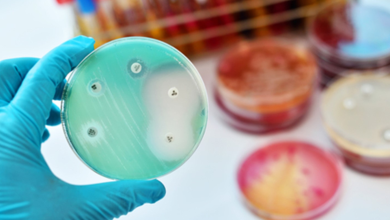

Mdagascar
-
Uncategorized

Madagascar: la résistance aux antimicrobiens cause 5400 décès chaque année
La résistance aux antimicrobiens (RAM) fait chaque année 5.400 décès à Madagascar, selon un communiqué récemment publié par le ministère…
Read More »
La résistance aux antimicrobiens (RAM) fait chaque année 5.400 décès à Madagascar, selon un communiqué récemment publié par le ministère…
Read More »